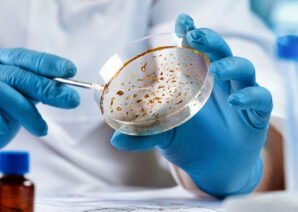

A fulldome show exploring the story of life on Earth, produced in-house by Life has won a prestigious international award.
Our blogs
Our digital documents

The Great Dinosaur Escape
The biggest collection of moving dinosaurs in the North arrives arrives at Life from Saturday 28 March.

Evolving Story of Life
For 25 years, Life has been a place where people go to discover science – whether it’s a child learning about space, or a researcher working on life-changing treatment.

Our Space Engagement Programme
This document highlights our approach to advancing space engagement and supporting the region’s space ambitions.

A Slice of Life
Over the last year, Life has continued its diverse purpose, to entertain, educate and inspire many different audiences. Read all about our 2023/24 headlines and highlights.

Climate Matters
As the North East’s biggest science centre, Life is committed to helping audiences make sense of climate science. Read about our unique perspective on a global challenge.

Schools' Programme
Find about about our programme for schools’ groups including a range of workshops linked to the curriculum.
Updates from Life’s Chief Executive
To stay abreast with the latest news from across our unique science hub, subscribe to our Chief Executive’s monthly newsletter.
Select ‘updates from Life’s Chief Executive’ when signing up and read past issues of the newsletter below.